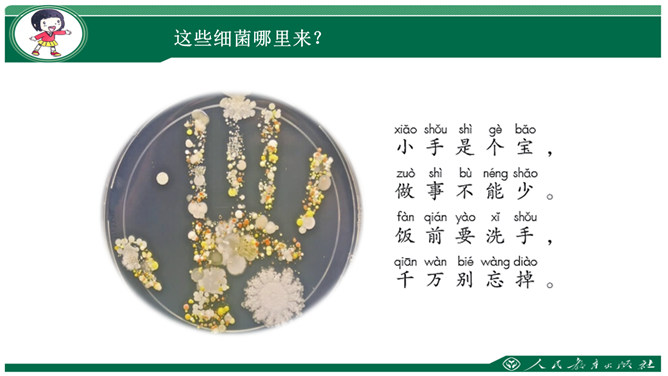

活动一:小小观察员“我们的手干净吗”。这个小朋友在餐桌上有什么表现?大家来说一说:在吃饭时,你都要做什么事情?打算怎样做?真烦,别夹给我了!好饿啊,我先吃吧。让开,让我挑块肉吃!我不想干!小结:每一类食物都含有不同的营养,同学们正在长身体的时候,需要各种营养帮助我们成长,所以我们每样食物都要吃一些,这样才能营养均衡,才能健康成长。所属专题:吃饭有讲究ppt。

活动一:小小观察员“我们的手干净吗”。这个小朋友在餐桌上有什么表现?大家来说一说:在吃饭时,你都要做什么事情?打算怎样做?真烦,别夹给我了!好饿啊,我先吃吧。让开,让我挑块肉吃!我不想干!小结:每一类食物都含有不同的营养,同学们正在长身体的时候,需要各种营养帮助我们成长,所以我们每样食物都要吃一些,这样才能营养均衡,才能健康成长。所属专题:吃饭有讲究ppt。